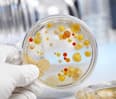
E. Coli and Salmonella Can Live In Food, Not Just On Food

Postmenopausal women who consumed 3.5 ounces (100 grams) of dried plums per day for 12 months had significantly better bone density.
The study also showed that dried plums changes key biochemistry markers, indicating that the process of excessive osteoclast activity had been slowed. This study elevates the plum to a level of a superfruit as far as your bones are concerned. The plum now joins a long list of other nutrients proven to benefit bone health.
The FDA-sanctioned bisphosphonate drugs, which actually make bones weaker the longer they are used, continue to be one of the greatest drug frauds ever perpetrated against the citizens of America.
The plums used in the study were provided by the California Dried Plum Board. I do have a word of caution for dried plum companies. If you post this study on your website then the FDA will come after your supply of plums, labeling them an unapproved new drug. The FDA has already done this with cherries and almonds.
The FDA has turned into a psychotic bully that does not want you to know how to be healthy and not need to take the fraudulent poisons they want you to consume. The FDA has become a major liability to the health and wellbeing of Americans.
Dried Plums in Your Diet Will Help Your Bones
Byron J. Richards, Board Certified Clinical Nutritionist